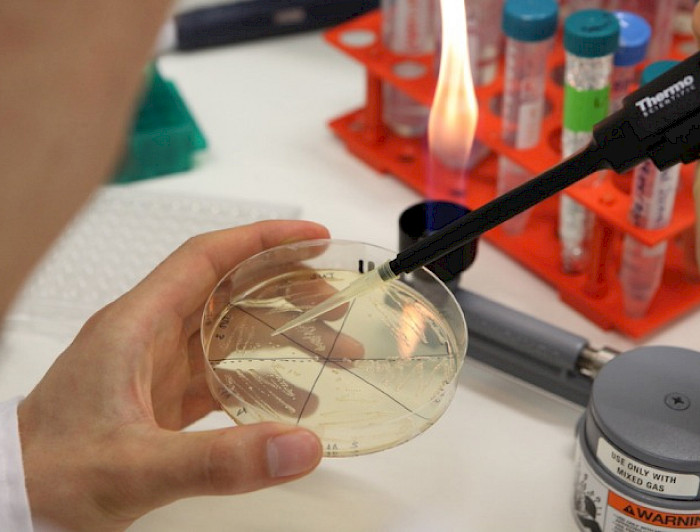
Análisis de muestra en laboratorio

Aporte del ministerio de Ciencias
Este ministerio presenta grandes y desafiantes tareas en beneficio del desarrollo del país. Por esto, sostiene el rector Ignacio Sánchez, “hay que invertir en lo prioritario y ciertamente la investigación en Ciencias y Humanidades es lo que va a significar la posibilidad de avanzar hacia un desarrollo integral e implementar los cambios que anhelamos para nuestra sociedad”.
La misión de las universidades es la formación integral de los jóvenes y la generación de nuevo conocimiento, apoyando el crecimiento de las Ciencias, las Humanidades y las Artes, en todas sus áreas de desarrollo. Así lo sostiene el rector Ignacio Sánchez en una columna que recogió La Segunda, este 7 de marzo. Respecto de ello apunta que el nuevo ministerio de Ciencia, Tecnología, Conocimiento e Innovación permitirá coordinar y promover las actividades de las ciencias, humanidades y tecnologías con el fin de avanzar hacia un desarrollo sustentable en beneficio de nuestra población. Este ministerio es el encargado de diseñar e implementar las políticas y programas destinados a fortalecer las ciencias y humanidades con el propósito de contribuir al desarrollo del patrimonio cultural, social y económico del país. En suma, dice, este ministerio presenta grandes y desafiantes tareas, responsabilidades a realizar en beneficio del desarrollo del país.
Según manifiesta la autoridad, se valoran las intervenciones que el ministro Andrés Couve ha tenido en el sentido de relevar la importancia de la inversión en ciencias. Así, con el fin de asumir los desafíos que se presentan, señala que es crucial que el país pueda incrementar la inversión pública y privada, para poder destinar nuevos recursos a estas tareas. Esto incluye invertir en nuevos proyectos de investigación; potenciar la formación doctoral; la reinserción de investigadores jóvenes; la implementación de equipamiento tecnológico mayor; la formación de nuevas redes internacionales; y la instalación de centros de innovación internacional con fuerte vinculación al sector productivo; entre otros. “Con preocupación, hemos visto que en la actualidad existe un gran número de investigadores en nuestro país con proyectos de gran calidad que no pueden ser financiados por falta de recursos. Por otra parte, los estudiantes de doctorado requieren de un apoyo más integral”, comenta.
Además, dice el rector que es fundamental el apoyo a las artes y humanidades, asegurando tener material bibliográfico de frontera y un activo intercambio académico. “Es crucial potenciar el desarrollo regional, con el fin de descentralizar la actividad científica”, advierte. Junto a ello, la creación de programas de educación y difusión de las ciencias en la etapa escolar y en la sociedad, va a permitir un futuro sustentable en investigación. Para esto, “es urgente que el ministerio, cuente con los recursos necesarios para desarrollar estas tareas”, afirma.
En este ámbito, sostiene que sin duda es importante considerar las restricciones presupuestarias del país, con focalización de los recursos públicos. Por esto, “hay que invertir en lo prioritario y ciertamente la investigación en ciencias y humanidades es lo que va a significar la posibilidad de avanzar hacia un desarrollo integral e implementar los cambios que anhelamos para nuestra sociedad. Esta inversión es el futuro del país y significará una mejor calidad de vida para nuestros habitantes. Debemos insistir en que no podemos postergar el desarrollo las ciencias y humanidades”, señala Sánchez.
Enlaces relacionados
Ministerio de Ciencias: grandes tareas y responsabilidades que no pueden ser postergadas
Desafíos para implementar el Ministerio de Ciencia y Tecnología





